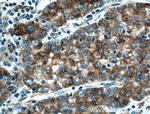
PTPN9 Antibody in Immunohistochemistry (Paraffin) (IHC (P))

Search
Proteintech
PTPN9 Polyclonal Antibody
{{$productOrderCtrl.translations['antibody.pdp.commerceCard.promotion.promotions']}}
{{$productOrderCtrl.translations['antibody.pdp.commerceCard.promotion.viewpromo']}}
{{$productOrderCtrl.translations['antibody.pdp.commerceCard.promotion.promocode']}}: {{promo.promoCode}} {{promo.promoTitle}} {{promo.promoDescription}}. {{$productOrderCtrl.translations['antibody.pdp.commerceCard.promotion.learnmore']}}
产品信息
12109-1-AP
种属反应
宿主/亚型
分类
类型
抗原
偶联物
形式
浓度
规格
纯化类型
保存液
内含物
保存条件
运输条件
产品详细信息
Immunogen sequence: FQFLPQVNG HPDPFDEIIL FSLPPALDWD SVHVPGPHAM TIQELVDYVN ARQKQGIYEE YEDIRRENPV GTFHCSMSPG NLEKNRYGDV PCLDQTRVKL TKRSGHTQTD YINASFMDGY KQKNAYIGTQ GPLENTYRDF WLMVWEQKVL VIVMTTRFEE GGRRKCGQYW PLEKDSRIRF GFLTVTNLGV ENMNHYKKTT LEIHNTEERQ KRQVTHFQFL SWPDYGVPSS AASLIDFLRV VRNQQSLAVS NMGARSKGQC PEPPIVVHCS AGIGRTGTFC SLDICLAQLE ELGTLNVFQT VSRMRTQRAF SIQTPEQYYF CYKAILEFAE KEGMVSSGQN LLAVESQ (248-663 aa encoded by BC010863 )
靶标信息
MEG2 is a member of the protein tyrosine phosphatase (PTP) family. PTPs are known to be signaling molecules that regulate a variety of cellular processes including cell growth, differentiation, mitotic cycle, and oncogenic transformation. This PTP contains an N-terminal domain that shares a significant similarity with yeast SEC14, which is a protein that has phosphatidylinositol transfer activity and is required for protein secretion through the Golgi complex in yeast. This PTP was found to be activated by polyphosphoinositide, and is thought to be involved in signaling events regulating phagocytosis.
仅用于科研。不用于诊断过程。未经明确授权不得转售。
生物信息学
蛋白别名: meg-2; Protein-tyrosine phosphatase MEG2; Protein-tyrosine phosphatase, non-receptor type 9 (Protein-tyrosine phosphatase MEG2) (PTPase-MEG2); PTPase MEG2; PTPase-MEG2; Tyrosine-protein phosphatase non-receptor type 9
基因别名: MEG2; PTPMEG2; PTPN9
UniProt ID: (Human) P43378, (Rat) Q641Z2, (Mouse) O35239
Entrez Gene ID: (Human) 5780, (Rat) 266611, (Mouse) 56294